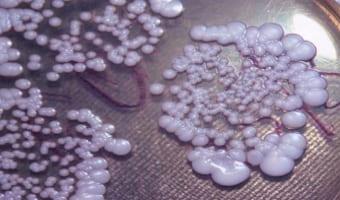
Молочница у женщины бальзаковского возраста

Боль в правом яичнике у женщин может указывать на различные заболевания, требующие внимания. Эти боли могут быть вызваны физиологическими процессами или серьезными патологиями, такими как воспаление, кисты или эндометриоз. В статье рассмотрим основные причины болей в правом яичнике, их характер и симптомы, что поможет женщинам распознать проблему и обратиться за медицинской помощью. Знание этих аспектов важно для сохранения здоровья и предотвращения осложнений.
Виды болей
Правый яичник может вызывать различные болевые ощущения. В зависимости от характера боли можно предположить возможные причины ее возникновения. Важно сообщить врачу о типе симптома, так как это может облегчить диагностику и помочь выбрать наиболее подходящие методы обследования для конкретного случая.
Виды болей в правом яичнике:
| Характер боли | Возможная причина |
|---|---|
| Тянущая | Менструация, киста яичника. Этот симптом может быть незначительным, но его продолжительность может сильно утомлять женщину. |
| Ноющая | Аднексит, овуляция, внематочная беременность, эндометриоз. Ноющие боли в правом яичнике обычно имеют низкую интенсивность, но могут усиливаться при ухудшении состояния. |
| Резкая | Крупные опухоли, перекрут ножки кисты, гиперстимуляция яичников. Этот признак появляется внезапно и также быстро исчезает. Часто сопровождается ноющими или тянущими болями. |
| Острая | Разрыв придатка, его кисты или фаллопиевой трубы при внематочной беременности. Во время овуляции могут возникать слабые острые боли в правом яичнике, которые обычно длятся не более суток. |
| Сильная | Апоплексия правого яичника или его кисты, перекрут ножки новообразования, внематочная беременность. При резких болях женщина часто вынуждена лечь, чтобы облегчить состояние. Часто наблюдается повышение температуры, холодный пот и предобморочное состояние. |
| Пульсирующая | Перекрут ножки кисты и/или придатка, их апоплексия. Пульсирующая боль в правом яичнике у женщин обычно свидетельствует о серьезных экстренных состояниях. Если симптом сохраняется более получаса, необходимо срочно обратиться к врачу. |
| Распространяющаяся по пояснице | Аднексит или оофорит. Часто возникает после переохлаждения. Основной признак простуженного правого яичника – тянущая боль внизу живота и дискомфорт в пояснице. |
| С иррадиацией в ногу | Крупная опухоль, гнойный воспалительный процесс. Обычно такая боль в правом яичнике, отдающая в ногу, сопровождается тянущими или ноющими болями различной силы. При наличии сильного воспаления часто наблюдается повышение температуры. |
Физиологическая боль обычно имеет низкую интенсивность и незначительно влияет на общее состояние женщины. Она указывает на изменения в организме, происходящие в течение менструального цикла – созревание фолликулов, их разрыв, подготовка матки к менструации и начало кровотечения. В случае патологий боли могут быть более выраженными и не зависеть от дня цикла.
Эксперты в области гинекологии отмечают, что боль в яичнике с правой стороны может быть вызвана различными факторами. Одной из наиболее распространенных причин является овуляция, когда фолликул разрывается, что может сопровождаться дискомфортом. Также стоит учитывать возможность наличия кист, которые могут образовываться на яичниках и вызывать болевые ощущения. Воспалительные процессы, такие как аднексит, также могут стать причиной боли. Кроме того, эксперты подчеркивают, что важно учитывать и другие состояния, такие как внематочная беременность или аппендицит, которые могут проявляться схожими симптомами. Поэтому при возникновении болей необходимо обратиться к врачу для точной диагностики и назначения соответствующего лечения.

Болезни яичников как причина болей
Существует ряд заболеваний правого яичника, которые могут вызывать дискомфорт. По характеру проявляемых симптомов можно оценить степень тяжести недуга и вероятность его распространения на левый яичник, матку и фаллопиевы трубы.
| Причина боли в правом яичнике | Симптомы (кроме боли) | Возможные дополнительные факторы |
|---|---|---|
| Овуляция | Кровянистые выделения, легкое вздутие живота | Стресс, гормональный дисбаланс |
| Киста яичника | Вздутие живота, тошнота, рвота, нарушения менструального цикла | Генетическая предрасположенность, эндометриоз |
| Аппендицит | Тошнота, рвота, лихорадка, потеря аппетита | Запор, диарея |
| Внематочная беременность | Кровотечение, головокружение, слабость | Задержка менструации, положительный тест на беременность |
| Эндометриоз | Сильные менструальные боли, боли во время полового акта, боли при мочеиспускании | Генетическая предрасположенность, гормональный дисбаланс |
| Воспалительные заболевания органов малого таза (ВЗОМТ) | Ненормальные выделения, лихорадка, боли при мочеиспускании и дефекации | Незащищенный половой акт, многочисленные половые партнеры |
| Сальпингит (воспаление маточных труб) | Лихорадка, слабость, боли при половом акте | Инфекции, передающиеся половым путем |
| Перекрут кисты яичника или яичника | Резкая, сильная боль | Физическая активность |
Интересные факты
Вот несколько интересных фактов о причинах боли в правом яичнике:
-
Овуляция: Одной из наиболее распространенных причин боли в правом яичнике является овуляция. Во время овуляции фолликул разрывается, что может вызвать кратковременную боль, известную как “mittelschmerz”. Эта боль обычно ощущается в середине менструального цикла и может быть как легкой, так и интенсивной.
-
Кисты яичников: Кисты, образующиеся на яичниках, могут вызывать боль, если они становятся большими или разрываются. Функциональные кисты, которые возникают в результате менструального цикла, чаще всего безвредны, но могут вызывать дискомфорт и боль.
-
Воспалительные заболевания органов малого таза (ВДОМП): Инфекции, такие как воспаление яичников или фаллопиевых труб, могут привести к сильной боли в правом яичнике. ВДОМП часто связаны с инфекциями, передающимися половым путем, и могут требовать медицинского вмешательства для предотвращения осложнений.
Эти факты подчеркивают важность обращения к врачу при возникновении болей в области яичников, чтобы определить точную причину и получить необходимое лечение.

Воспалительные процессы
К указанным типам заболеваний относятся оофорит и аднексит. В процессе их развития воспаление затрагивает придатки, что приводит к их увеличению и отечности. Это состояние сопровождается тянущими болями в области правого яичника, которые могут иррадиировать в поясницу.
Болевой синдром при воспалении проявляется постоянно. В случае острого течения болезни боль возникает внезапно и отличается высокой интенсивностью, которая постепенно снижается по мере выздоровления. Хронический оофорит, в свою очередь, характеризуется периодическими незначительными болями в правом яичнике.
Инфекционное поражение
Инфекции, грибковые заболевания и другие микроорганизмы могут вызывать воспалительные процессы в затронутых органах. Изолированное инфицирование правого яичника встречается довольно редко, так как патогенные бактерии обычно проникают в половые органы через влагалище. Чаще всего придатки заражаются после матки и фаллопиевых труб.
Инфекционные процессы у женщин могут проявляться ноющими болями в области правого яичника. Однако данная патология может развиваться и без выраженного болевого синдрома. Одним из характерных признаков наличия патогенных микроорганизмов в половых путях является изменение характера влагалищных выделений, которые могут приобретать желтоватый или зеленоватый цвет и неприятный запах.

Правосторонний аднексит
Аднексит представляет собой инфекционное воспаление правого яичника и его маточной трубы. Основными возбудителями этого заболевания являются кандида, микоплазма, уреаплазма и хламидии. Боль, возникающая при данной патологии, локализуется в области пораженного органа и имеет ноющий характер, часто отдавая в поясницу. Этот симптом может периодически ослабевать и вновь усиливаться, что указывает на запущенность аднексита.
Если возникает боль с правой стороны яичника и температура тела поднимается выше 37 градусов, это может свидетельствовать об остром или подостром аднексите. Лечение в таком случае необходимо начинать незамедлительно, иначе заболевание может перейти в хроническую форму.
Апоплексия органа
Разрыв правого яичника проявляется резкими и интенсивными болями в этой области. Кроме того, могут возникать симптомы, такие как холодный пот, снижение артериального давления и учащенное сердцебиение. В некоторых случаях возможно предобморочное состояние или даже обморок. Спустя некоторое время после апоплексии болевой синдром может охватить всю область живота, что затрудняет диагностику данного состояния.
При первых признаках разрыва придатка женщину следует срочно доставить в медицинское учреждение. Отказ от лечения или задержка в оказании помощи могут привести к развитию перитонита, что представляет серьезную угрозу для жизни и здоровья пациентки.
В некоторых случаях для предотвращения серьезных последствий может потребоваться удаление яичника. Эта процедура может быть выполнена с помощью лапароскопии или лапаротомии. Второй метод применяется, если состояние женщины тяжелое. В период восстановления после удаления яичника может наблюдаться боль в правом боку, которая, как правило, не должна длиться более месяца.
Аномалии расположения половых органов
Необычное положение яичников может быть как врожденной аномалией, так и результатом приобретенной патологии. В случае появления болей в области придатков, а также при высоком риске перекручивания их ножек или разрыва во время беременности, может потребоваться хирургическое вмешательство.
Болевые ощущения при атипичном расположении правого яичника имеют острый характер. Они могут усиливаться при физической активности или поднятии тяжестей. Часто аномальное положение органов проявляется во время полового акта, вызывая дискомфорт в правом боку, в области яичника.
Кисты и опухоли
Небольшие новообразования в яичниках зачастую не проявляют себя симптоматически. Однако, при увеличении их размера может возникать тянущая боль в правой нижней части живота. Функциональные кисты нередко становятся причиной нарушения менструального цикла, что выражается в длительных задержках менструации.
При наличии опухоли или крупной кисты правого яичника боль может усиливаться во время физической активности, половых контактов или при поднятии тяжестей. Образования, превышающие 10 см, способны вызывать острые болевые ощущения, которые могут иррадиировать в ногу или крестец из-за сдавления нервных окончаний. У некоторых женщин боль в области правого яичника становится настолько интенсивной, что приводит к онемению ноги и затрудняет передвижение. Это особенно актуально для опухолей диаметром более 20 см.
Апоплексия кисты
Острая патология обычно требует проведения хирургической операции. Признаки разрыва кисты аналогичны симптомам апоплексии яичника. Это состояние представляет собой серьезную угрозу из-за возможности возникновения обширного воспалительного процесса, который может развиться вследствие внутреннего кровотечения и попадания содержимого кисты в брюшную полость.
Перекрут ножки кисты
Боль в правой нижней части живота может быть резкой. Симптоматика напоминает разрыв кисты, однако проявления менее интенсивны. Перекручивание ножки капсулы требует срочного вмешательства врачей, так как в противном случае существует высокий риск апоплексии как самого образования, так и яичника.
Гиперстимуляция яичников
Развитие синдрома гиперстимуляции яичников происходит в результате применения препаратов, содержащих синтетические аналоги половых гормонов для стимуляции овуляции. Неправильный выбор терапии или превышение рекомендуемых доз может привести к увеличению объема яичников, что вызывает дискомфорт в этой области. В некоторых случаях это может привести к поликистозу яичников, характеризующемуся образованием множества функциональных кист.
Боли в правом яичнике при гиперстимуляции чаще всего усиливаются в первую фазу менструального цикла.
При неправильном лечении и отсутствии овуляции могут наблюдаться такие симптомы, как увеличение веса, перепады настроения, выпадение волос и другие проявления гормонального дисбаланса. Также возможно усиление болевых ощущений в правом яичнике во время менструации. Это может стать причиной для пациентки прекратить текущую терапию или рассмотреть возможность замены препаратов.
Физиологические причины
В течение менструального цикла и в период естественных гормональных изменений женщины могут испытывать дискомфорт в области живота. Это явление обусловлено физиологическими процессами в организме и, как правило, не угрожает здоровью. Однако, если такой симптом появляется, рекомендуется обратиться к гинекологу для исключения возможных патологий.
Первая фаза цикла и овуляция
На первом этапе менструального цикла в правом яичнике происходит развитие фолликулов, содержащих яйцеклетку. Непосредственно перед овуляцией остаются только 1-2 пузырька, готовых к разрыву. Их активный рост может сопровождаться легкими тянущими или ноющими болями.
Во время овуляции фолликул достигает своего максимального размера. В этот период женщина может испытывать небольшой дискомфорт, а при разрыве фолликула – легкую колющую боль. Это связано с повышением местного кровообращения, что делает мягкие ткани более чувствительными.
Боль в правом яичнике после овуляции возникает из-за формирования желтого тела, которое образуется на месте разорвавшегося фолликула.
Менструация
Во время менструации многие женщины испытывают дискомфорт и боли в области живота. Эти ощущения обычно сосредоточены в матке и возникают из-за отторжения эндометрия. В некоторых случаях может возникать боль в правом яичнике, что связано с регрессией желтого тела и его выведением из организма вместе с менструальной кровью, а также с естественными изменениями в гормональном фоне.
Если сильная боль в правом яичнике появляется с началом менструации и не наблюдалась в предыдущих циклах, это может указывать на наличие патологий придатков.
За несколько дней до начала менструации организм начинает подготовку к кровотечению. У некоторых женщин этот период проходит без каких-либо симптомов, в то время как другие могут ощущать легкие боли в матке и правом яичнике перед месячными. Эти боли, как правило, незначительные и редко вызывают серьезный дискомфорт.
Период беременности
Боли в области правого яичника во время беременности, как правило, имеют физиологическую природу. Они возникают из-за давления растущей матки на соседние органы и растяжения связок. Женщины часто ощущают дискомфорт в нижней части живота, однако при отсутствии каких-либо патологий это считается нормальным явлением. Физиологические боли в яичнике могут наблюдаться только в первые недели беременности, так как они связаны с увеличением желтого тела, которое необходимо для выработки прогестерона.
Слабая колющая боль в правом яичнике, сопровождающаяся тошнотой и задержкой менструации, может указывать на успешное зачатие.
Болевые ощущения непосредственно в яичнике встречаются довольно редко. Это связано с тем, что функциональность придатка снижается во время беременности, а также частично в период грудного вскармливания. Появление болей может сигнализировать о наличии кистозных образований или воспалительных процессов в органе.
Послеродовой период
После рождения ребенка яичники женщины некоторое время остаются в состоянии покоя. Они начинают функционировать быстрее всего после прекращения грудного вскармливания, а во время лактации отсутствие менструаций до полутора лет считается нормальным. В среднем яичники активизируются через 3-6 месяцев, что может сопровождаться болевыми ощущениями. Эти боли обусловлены восстановлением органов до привычного размера, началом роста фолликулов и выработкой половых гормонов.
Боли в области правого яичника могут сохраняться до двух месяцев после родов. Их появление связано с восстановительными процессами в половых органах, особенно в матке. Дискомфорт может ощущаться в матке, а также в связках малого таза и влагалище. Некоторые женщины могут ошибочно воспринимать эти ощущения как боли в придатках. Обычно такие симптомы имеют низкую интенсивность и не должны существенно влиять на общее самочувствие женщины или снижать ее работоспособность.
Возрастные особенности болевого синдрома
Боли в правом яичнике могут возникать в результате естественных гормональных изменений. К таким периодам относятся не только беременность и первые месяцы после родов, но и подростковый возраст, а также климакс. У девочек-подростков дискомфорт часто связан с увеличением размеров яичников, началом их гормональной активности и формированием менструального цикла. Обычно это происходит в возрасте от 12 до 14 лет. Если боли становятся интенсивными и регулярными, рекомендуется обратиться к гинекологу.
С началом подросткового периода рекомендуется посещать врача для профилактики заболеваний половой системы 1-2 раза в год.
Во время климакса боли в правом яичнике могут быть связаны со снижением функции половых органов и прекращением их эндокринной активности. Одной из причин этих симптомов является опущение органов малого таза, что является естественным следствием старения организма. Болевые ощущения могут сохраняться до полного наступления климакса и продолжаться на протяжении нескольких лет.
Другие причины
Боли в правом яичнике могут быть вызваны заболеваниями соседних органов. Поскольку они находятся близко друг к другу, точно определить источник боли возможно лишь с помощью диагностики.
Внематочная беременность
Внематочная беременность нуждается в тщательном медицинском наблюдении и срочном проведении аборта. Если не принять меры, развитие плода может привести к разрыву фаллопиевой трубы. Обычно этому предшествует сильная боль в правом яичнике у женщины, сопровождающаяся длительной задержкой менструации. В данной ситуации крайне важно незамедлительно обратиться за медицинской помощью.
Эндометриоз и миома
Заболевание начинается в матке, где формируется миома в ее тканях. Эндометриоз, в свою очередь, проявляется в виде разрастания эндометрия матки. В запущенных случаях очаги этой болезни могут затрагивать фаллопиевы трубы и яичники.
Болевые ощущения обычно сосредоточены в области матки. Из-за близкого расположения органов их можно ошибочно принять за боль в правом яичнике. Сам придаток может испытывать дискомфорт только в случае его поражения эндометриозом или сдавливания крупной миомой матки.
Цистит
Воспаление мочевого пузыря. Это состояние характеризуется острыми болями в нижней части живота и пояснице, а также резью при мочеиспускании и повышением температуры. Часто женщины могут спутать цистит с заболеваниями яичников и другими гинекологическими проблемами. Однако ключевым признаком, который помогает отличить эту патологию от гинекологических заболеваний, является постоянное желание опорожнить мочевой пузырь, что приводит к мочеиспусканию небольшими порциями примерно 15-20 раз в день.
Молочница
Грибковая инфекция половых органов. Боли в правом яичнике могут возникать при молочнице, особенно если заболевание запущено и не получило должного лечения. Основные симптомы включают обильные творожистые выделения из влагалища с характерным кислым запахом, а также зуд в области наружных половых органов. Инфекция может принимать хроническую форму, проявляясь периодическими обострениями.
Лечение молочницы может быть затруднено, если у пациента имеются проблемы с регулярностью стула, так как грибки часто размножаются в кишечнике.
Интимная близость
Боль в правом яичнике во время полового акта может возникать по ряду причин, связанных с различными заболеваниями. Женщина может ощущать дискомфорт при наличии воспалительных процессов в матке и яичниках, инфекциях половых путей, кистах яичника или спаечных процессах. Однако болевые ощущения могут также не иметь отношения к заболеваниям и возникать из-за неудобных поз или слишком активного соития.
После интимной близости, особенно при наличии кисты или других заболеваний, могут наблюдаться боли в правом яичнике и коричневые выделения из влагалища.
Хронические боли в малом тазу
Это состояние устанавливается, если боли в области яичников и малого таза продолжаются более шести месяцев. Наиболее распространенной причиной данного симптома являются хронические гинекологические заболевания. Кроме того, к другим возможным патологиям, приводящим к дискомфорту, можно отнести спаечный процесс, а также заболевания кишечника, мочевого пузыря и позвоночника.
Методы диагностики
Для предотвращения заболеваний правого яичника важно пройти всестороннюю диагностику, которая включает как лабораторные, так и инструментальные исследования. Женщинам обычно назначаются следующие процедуры:
- Сбор анамнеза. Необходимо выяснить, когда появились симптомы, их интенсивность, наличие ранее диагностированных заболеваний половой системы, особенности менструального цикла, а также информацию о родах и абортах.
- Гинекологический осмотр. В ходе этого этапа проводится пальпация матки и обоих яичников для определения болезненности, наличия новообразований и увеличения органов.
- Мазок из влагалища. Этот анализ позволяет оценить состояние местной микрофлоры и выявить наличие инфекций или грибковых заболеваний.
- Анализы на гормоны. Рекомендуется проверить уровень эстрадиола, прогестерона, пролактина, а также соотношение ФСГ и ЛГ.
- УЗИ. Данное исследование позволяет осмотреть внутренние половые органы, измерить их объем и толщину, а также выявить воспалительные процессы.
- КТ и МРТ. Эти методы обеспечивают детальную оценку состояния правого яичника, окружающих органов, сосудов и лимфатических узлов.
- Общий и биохимический анализ крови. Эти анализы помогают получить общую картину здоровья организма и выявить воспалительные или инфекционные процессы.
- Лапароскопия. Этот малоинвазивный метод используется в случаях, когда другие исследования не дали результатов, в экстренных ситуациях или для определения типа опухоли с помощью биопсии.
Как правило, назначается лишь несколько из указанных исследований. В первую очередь проводятся гинекологический осмотр, забор мазка и УЗИ органов малого таза. Если возникают патологические боли в правом яичнике и диагноз остается неясным, могут быть назначены дополнительные исследования.
Способы лечения
Большинство заболеваний придатков обусловлено гормональным дисбалансом. Они могут проявляться нарушениями менструального цикла и образованием функциональных кист. Для лечения правого яичника применяются следующие группы препаратов:
- содержащие эстроген;
- содержащие прогестерон;
- препараты, стимулирующие овуляцию;
- оральные контрацептивы;
- витамины.
Курс терапии обычно длится от 3 до 6 месяцев. Если результаты отсутствуют, врач может назначить другие медикаменты.
Часто на фоне гормонального лечения пациенты испытывают дискомфорт в нижней части живота. Например, после приема Клостилбегита или Диферелина в дозировке 3.75 мг могут возникать боли в правом яичнике. Это считается побочным эффектом и указывает на изменение гормонального фона, необходимого для решения проблемы. Для контроля за лечением требуется проводить УЗИ и регулярно сдавать анализы на гормоны. При сильных болях важно сообщить об этом лечащему врачу.
Для лечения воспалительных и инфекционных заболеваний необходимо использовать другие группы препаратов:
- противовоспалительные средства;
- антибиотики;
- обезболивающие;
- нестероидные противовоспалительные препараты;
- противогрибковые средства;
- вагинальные свечи местного действия.
Средняя продолжительность такого лечения составляет 10-14 дней. За этот период устраняются все симптомы заболевания, включая боли в правом яичнике, и восстанавливается функция половых органов.
Для удаления доброкачественных и злокачественных опухолей, крупных кист и обширных спаек требуется хирургическое вмешательство.
Народные средства
Некоторые заболевания, сопровождающиеся болями в правом яичнике, могут быть лечены с использованием народных средств. Врач может рекомендовать определенные травы, обладающие необходимыми свойствами для лечения. Вот наиболее популярные и действенные из них:
- Ромашка. Эффективна при инфекциях и воспалениях. Используется как в виде отваров для внутреннего приема, так и для приготовления ванночек. Обладает антибактериальными, противовоспалительными, обезболивающими, успокаивающими и мочегонными свойствами.
- Сок алоэ. Применяется внутрь как средство для снятия боли.
- Можжевельник. Для лечения используются ягоды, которые можно есть в сыром виде или готовить из них отвары. Обладает противомикробными, обезболивающими и тонизирующими эффектами.
- Белая акация. Это мощное противовоспалительное средство, которое назначается в виде отваров и для влагалищных спринцеваний.
- Лопух. Обладает противогрибковыми, антибактериальными и противоопухолевыми свойствами. Часто используется при воспалительных процессах в правом яичнике или при наличии опухолей, принимается внутрь в виде измельченной кашицы.
Перед использованием народных средств обязательно проконсультируйтесь с врачом. Некоторые из них могут быть несовместимы с медикаментами, содержащими синтетические гормоны.
Профилактика
Чтобы избежать патологических болей в правом яичнике, важно заботиться о здоровье половых органов. Женщинам стоит придерживаться ряда рекомендаций от специалистов:
- посещать гинеколога дважды в год;
- применять барьерные методы контрацепции;
- следить за сбалансированным питанием;
- принимать лекарства только по назначению врача;
- соблюдать ежедневную личную гигиену;
- организовывать полноценный отдых.
Физиологические боли в правом яичнике предотвратить невозможно, так как они связаны с индивидуальными особенностями организма, включая повышенную чувствительность. Для снижения их интенсивности рекомендуется регулярно употреблять витаминные комплексы и правильно питаться. В случае сильных болей можно использовать обезболивающие препараты.
Если возникают боли в правом яичнике, женщине следует пройти полное обследование у гинеколога. Лечение может быть назначено только на основе результатов анализов. Самостоятельная терапия может усугубить текущее состояние. Для профилактики заболеваний придатков рекомендуется посещать врача каждые полгода.
Психосоматические факторы
Психосоматические факторы играют важную роль в возникновении и проявлении боли в яичнике с правой стороны. Психосоматика изучает, как эмоциональные и психологические состояния могут влиять на физическое здоровье, и в данном случае, стресс, тревога и депрессия могут быть значительными триггерами болевых ощущений.
Одним из основных аспектов психосоматических факторов является связь между эмоциональным состоянием и физиологическими реакциями организма. Например, хронический стресс может приводить к напряжению мышц, что, в свою очередь, может вызывать дискомфорт в области живота и таза, включая область яичников. Это напряжение может быть как прямым следствием эмоционального стресса, так и результатом неосознанного сжатия мышц в ответ на тревожные мысли.
Кроме того, психосоматические расстройства могут проявляться через различные физические симптомы, включая боль в яичниках. Например, у женщин, переживающих эмоциональные потрясения или стрессовые ситуации, может наблюдаться обострение предменструального синдрома (ПМС), который часто сопровождается болями в области яичников. ПМС может усугубляться эмоциональным состоянием, что приводит к усилению болевых ощущений.
Также стоит отметить, что подавленные эмоции, такие как гнев или печаль, могут находить выход в виде физических симптомов. Женщины, которые не могут или не хотят выражать свои чувства, могут испытывать боли в области яичников как способ проявления внутреннего конфликта. Это может быть связано с тем, что яичники и репродуктивная система в целом часто ассоциируются с женственностью, материнством и эмоциональной сферой.
Важно понимать, что психосоматические факторы не означают, что боль в яичниках является «вымышленной» или «не настоящей». Физические ощущения, вызванные психосоматическими механизмами, могут быть столь же интенсивными и реальными, как и боли, вызванные органическими заболеваниями. Поэтому при возникновении болей в яичниках важно учитывать не только физические, но и эмоциональные аспекты здоровья.
Для диагностики и лечения психосоматических болей может потребоваться комплексный подход, включающий как медицинское, так и психологическое вмешательство. Консультация с психотерапевтом или психологом может помочь выявить и проработать эмоциональные проблемы, которые могут способствовать возникновению болей. В некоторых случаях может быть полезно сочетание психотерапии с физиотерапией или другими методами лечения, направленными на снятие мышечного напряжения и улучшение общего состояния здоровья.
Вопрос-ответ
Какие основные причины боли в правом яичнике?
Боль в правом яичнике может быть вызвана различными факторами, включая овуляцию, кисты яичников, воспалительные заболевания органов малого таза, а также аппендицит. Важно учитывать, что каждая причина требует индивидуального подхода к диагностике и лечению.
Когда следует обратиться к врачу при боли в яичнике?
Если боль в правом яичнике сопровождается сильными спазмами, повышенной температурой, необычными выделениями или длится более нескольких дней, необходимо обратиться к врачу. Эти симптомы могут указывать на более серьезные проблемы, требующие медицинского вмешательства.
Как можно облегчить боль в яичнике до обращения к врачу?
Для временного облегчения боли можно использовать теплые компрессы на область живота, принимать обезболивающие препараты, такие как ибупрофен или парацетамол, и избегать физической активности. Однако это не заменяет консультацию специалиста.
Советы
СОВЕТ №1
Если вы испытываете боль в правом яичнике, не игнорируйте симптомы. Обратите внимание на характер боли: острая, тупая или схваткообразная. Это поможет врачу быстрее поставить диагноз.
СОВЕТ №2
Записывайте все сопутствующие симптомы, такие как изменения в менструальном цикле, тошнота или температура. Эта информация будет полезна при обращении к врачу.
СОВЕТ №3
Не занимайтесь самолечением. При появлении боли в яичниках лучше всего обратиться к специалисту для проведения необходимых обследований и исключения серьезных заболеваний.
СОВЕТ №4
Регулярно проходите профилактические осмотры у гинеколога. Это поможет выявить возможные проблемы на ранних стадиях и предотвратить развитие осложнений.